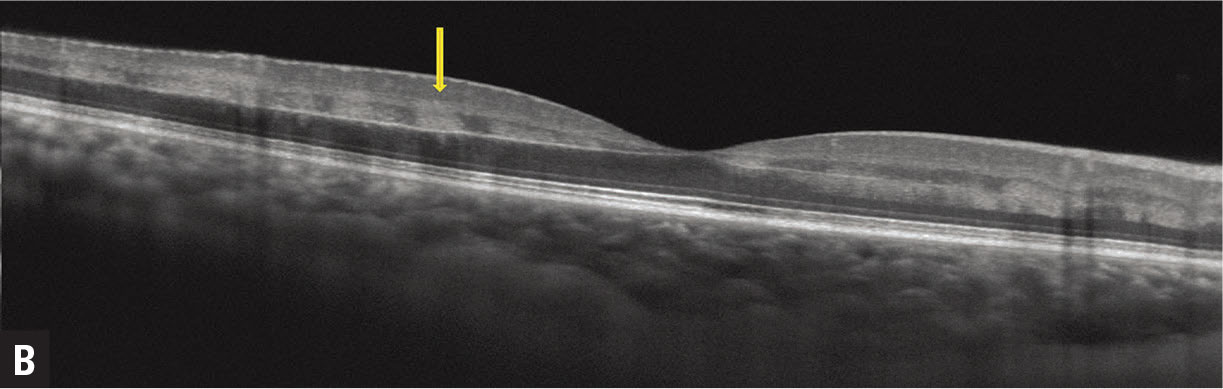
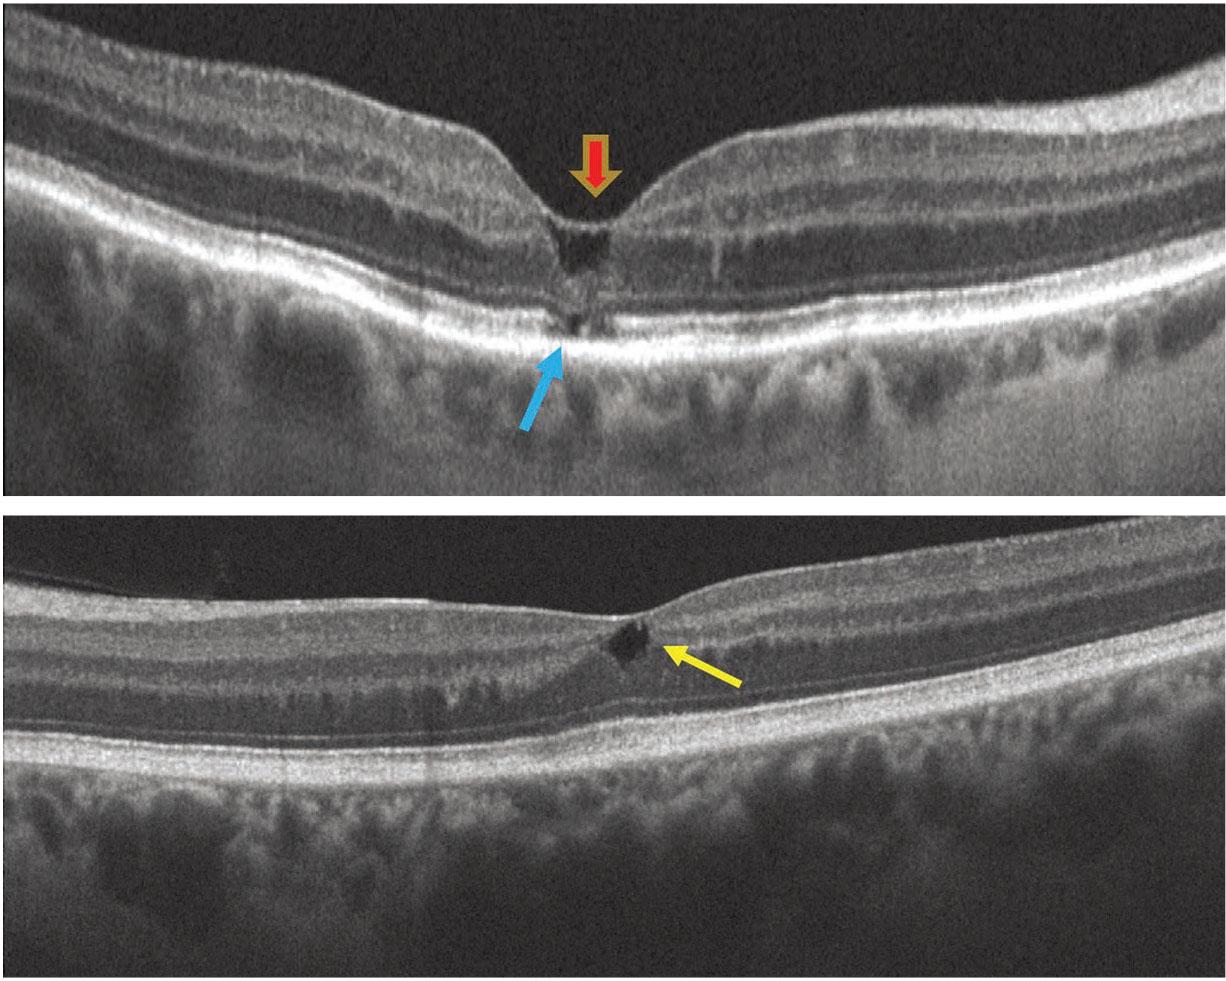

| New Insights in Imaging |
Take-home points
|
![]() |
|
Bios DISCLOSURES: Dr. Baumal is a consultant to Genentech, Ora, Novartis and EyePoint Pharmaceuticals, and a speaker for Regeneron |
![]() |
![]() |
![]() |
|
Figure 1. In central retinal vein occlusion with paracentral acute middle maculopathy (PAMM), color fundus photography (A) shows retinal venous tortuosity, small-dot retinal hemorrhages and optic nerve hyperemia. Note the deep retinal whitening adjacent the retinal veins temporal to the fovea. B) Hyper-reflective focal band-like lesions (yellow arrow) in the middle retina (inner nuclear layer, inner plexiform, outer plexiform layers) on spectral-domain optical coherence tomography are consistent with PAMM. C) Distinct en face OCT appearance with a perivenular pattern described as fern-like PAMM. |
Optical coherence tomography imaging of the retina has come a long way since the first prototype OCT device was used to evaluate patients in the 1990s in a collaboration between James Fujimoto’s lab at Massachusetts Institute of Technology and clinicians at the New England Eye Center.1
In the 25-year journey of commercial OCT machines in the ophthalmology clinic, the images acquired have drastically improved with current spectral-domain and swept-source devices. This has given us better diagnostics and an increased understanding of disease pathogenesis, and enabled OCT to direct our therapeutic decisions.
For example, use of the grayscale over the false color OCT imaging has improved visualization of subtle reflectivity that may be associated with retinal disorders. Multimodal imaging using complementary technologies has confirmed OCT findings of retinal disorders.2
Characteristic OCT findings have emerged that can help narrow or even confirm a novel diagnosis. Last year we reviewed some of these findings.3 This article will highlight some of them, including paracentral acute middle maculopathy (PAMM), acute macular neuroretinopathy (AMN), macular telangiectasia (MacTel) type 2 and hemorrhage in the Henle fiber layer. Table 1 lists some novel findings.
Paracentral acute middle maculopathy
PAMM refers to a SD-OCT finding characterized by hyperreflective discontinuous band like lesions, primarily located in the inner nuclear layer (INL).4 It’s hypothesized that these lesions result from ischemia or insult to the intermediate and deep retinal capillary plexus.5
The OCT features of PAMM are distinctive (Figure 1), and are more readily recognized when clinicians realize that structural grayscale SD-OCT images offer greater visibility of subtle OCT reflectivity compared to the false color scale.
PAMM represents an imaging finding that may help narrow the diagnostic spectrum, rather than suggest a single diagnosis. PAMM was initially described in isolation, but subsequently it has been observed in conjunction with many other disorders, most prominently retinal vascular and systemic disorders, including branch retinal artery occlusion, central retinal artery occlusion, central retinal vein occlusion, diabetic retinopathy, sickle cell retinopathy and Purtscher retinopathy.6-9
OCT angiography and en face OCT patterns, described as fern-like, arteriolar and globular, have been used to further characterize PAMM.10 Diagnosis of PAMM warrants a directed history to identify potential causes and a systemic evaluation to exclude vascular risk factors. An underlying cause may not be identified.
Table 1. Novel optical coherence tomography findings | |
|
|
| Adapted from Baumal C. Novel OCT findings. Paper presented at American Academy of Ophthalmology 2021 Retina Subspecialty Day; New Orleans, LA; November 13, 2022. | |
![]() |
|
Figure 2. In acute macular neuroretinopathy, color fundus photography (A,B) reveals reddish-brown petaloid (n on elevated) perifoveal lesions with the tip pointed toward the fovea in a young woman presenting with bilateral scotomas. C,D) Spectral-domain optical coherence tomography (C right eye, D left) acutely through the lesion reveals a horizontal band of hyperreflectivity anterior to the retinal pigment epithelium between the outer plexiform and outer nuclear layers corresponding to the lesions. E,F) SD-OCT (E right eye, F left) two weeks after presentation shows disruption and loss of the ellipsoid and interdigitation zones corresponding to the acute lesions. |
Acute macular neuroretinopathy
In contrast to PAMM, AMN in the acute phase features a horizontal band of hyperreflectivity anterior to the RPE between the outer plexiform and outer nuclear layers (Figure 2).11 Thus, the anatomic location of hyperreflectivity differs between AMN and PAMM. Where the hyperreflectivity in PAMM is more anterior at the level of the INL, eyes with AMN also demonstrate bilateral subtle dark gray wedge-shaped lesions on near infrared reflectance or en face OCT, corresponding to red-brown lesions on color fundus photography.
The acute phase of the OCT hyperreflective band in AMN may be brief. By the time the patient presents complaining of paracentral scotomas, the OCT may show the later findings of thinning, and disruption of the outer retina and ellipsoid/interdigitation zones.12,13
AMN is rarer than PAMM. An appropriate history and focused systemic evaluation are indicated to assess for potential associations, which may include oral contraceptives, epinephrine use, hypotension, trauma, flu-like syndrome and systemic lupus.
Macular telangiectasia type 2
In MacTel type 2, OCT may show degenerative hyporeflective outer retinal cyst (or cavitation) located at various retinal depths along with asymmetry or irregularity of the fovea contour (Figure 3).13 Other findings include hyperreflectivity at the middle retinal layers, outward bending of inner retinal layers, retinal pigment clumps with shadowing of the deep retina, superficial retinal crystals, vitelliform lesion, internal limiting membrane drape and disruption of the external limiting membrane, ellipsoid and interdigitation zones.14-16
ILM drape is described as a thin layer of ILM over a superficial retinal lucency, which may represent residual foot plates of Muller cells. Vision loss may be related to ILM drape and outer retinal degeneration. Macular hole and choroidal neovascularization may ultimately develop.
![]() |
|
Figure 3. In macular telangiectasia type 2, spectral-domain optical coherence tomography of the right eye (A) shows internal limiting membrane drape (red arrow), outward collapse of the retinal layers and external limiting membrane, ellipsoid, interdigitation zone loss (blue arrow). B) SD-OCT of the left eye reveals an inner retinal degenerative cystic space. The fovea contour is irregular in both eyes. |
MacTel type 2 affects the macular Müller cells and capillary network, leading to the anatomical changes in the inner and outer retinal structure.17 Multimodal imaging, including OCT angiography and fluorescein angiography, may corroborate the diagnosis and exclude choroidal neovascularization.
| Table 2. Etiology of Henle fiber layer hemorrhage |
| Systemic central venous pressure (CVP) abnormality
Local retinovascular abnormality affecting the deep capillary plexus
Choroidal vascular abnormality with breakthrough into Henle fiber layer
Adapted from Baumal CR, Sarraf D, Bryant T, et al. Henle fibre layer haemorrhage: Clinical features and pathogenesis. Br J Ophthalmol. 2021;105:374-380 |
Henle fiber layer hemorrhage
OCT findings of blood located within Henle fiber layer (HFL), referred to as Henle fiber layer hemorrhage or HH, have been described as characteristic hyperreflectivity from the hemorrhage delineated by the obliquely oriented fibers in the Henle layer (Figure 4).18 Clinical findings demonstrate deep hemorrhages that may exhibit a feathery margin and petaloid pattern radiating from the fovea or have a rounder appearance when located peripheral to the macula.
![]() |
Figure 4. In Henle nerve fiber layer hemorrhage in a branch retinal vein occlusion, spectral-domain optical coherence tomography of the left eye shows oblique hyperreflectivity (yellow/green arrows) separated by hyporeflective striations corresponding to deep retinal hemorrhages in Henle fiber layer. The inset shows the near-infrared image. (Courtesy David Sarraf, MD) |
![]() |
The HFL consists of long, cylindrical, unmyelinated cone and rod axons that synapse in the outer plexiform layer. The fibers are radially orientated around the fovea due to the embryologic development of the foveal pit. The oblique orientation of fibers in HFL coursing at an angle account for the petaloid shape of Henle hemorrhages as well as the feathery margins when located around the fovea.
Henle hemorrhage may result from a wide variety of pathologies (Table 2, page 22) and can be classified as secondary to local vascular abnormalities of the deep capillary plexus, choroidal vascular abnormalities or disorders affecting central venous pressure. Henle hemorrhage has been described in association with MacTel type 2, where the source of the blood likely originates from the deep retinal capillary plexus as it’s positioned adjacent to the HFL.19
Bottom line
Even though OCT has been available in the clinic for more than two decades, novel findings continue to be described that may be based on OCT appearance, a description of the anatomy or disease pathogenesis. Table 1 describes a miniscule number of these novel findings from the recent literature. With careful observation, many of these findings can be observed and more novel OCT findings will be uncovered. RS
REFERENCES
1. Fujimoto J, Brezinski M, Tearney G. et al. Optical biopsy and imaging using optical coherence tomography. Nat Med. 1995;1: 970–972
2. Novais EA, Baumal CR, Sarraf D, Freund, KB, Duker JS. Multimodal imaging in retina disease: A consensus definition. OSLI Retina. 2016;47:201-205.
3. Baumal C. Novel OCT findings. Paper presented at American Academy of Ophthalmology 2021 Retina Subspecialty Day; New Orleans, LA; November 13, 2022.
4. Sarraf D, Rahimy E, Fawzi AA, et al. Paracentral acute middle maculopathy: a new variant of acute macular neuroretinopathy associated with retinal capillary ischemia. JAMA Ophthalmol. 2013;131:1275-1287.
5. Bakhoum MF, Freund KB, Dolz-Marco R, et al. Paracentral acute middle maculopathy and the ischemic cascade associated with retinal vascular occlusion. Am J Ophthalmol. 2018;195:143-153.
6. Rahimy E, Sarraf D, Dollin ML, Pitcher JD, Ho AC. Paracentral acute middle maculopathy in nonischemic central retinal vein occlusion. Am J Ophthalmol. 2014;158:372-380.
7. Casalino G, Williams M, McAvoy C, Bandello F, Chakravarthy U. Optical coherence tomography angiography in paracentral acute middle maculopathy secondary to central retinal vein occlusion. Eye (Lond). 2016;30:888-893.
8. Chen X, Rahimy E, Sergott RC, et al. Spectrum of retinal vascular diseases associated with paracentral acute middle maculopathy. Am J Ophthalmol. 2015;160:26-34.e1
9. Chen X, Baumal CR. Paracentral middle acute maculopathy in pregnancy. Retina Cases Brief Rep. 2020;14:221-223.
10. Sridhar J, Shahlaee A, Rahimy E, et al. Optical coherence tomography angiography and en face optical coherence tomography features of paracentral acute middle maculopathy. Am J Ophthalmol. 2015;160:1259-1268.
11. Monson BK, Greenberg PB, Greenberg E, et al. High-speed, ultra-high-resolution optical coherence tomography of acute macular neuroretinopathy. Br J Ophthalmol. 2007;19:119-120.
12. Dansingani KK, Freund KB. Paracentral acute middle maculopathy and acute macular neuroretinopathy: Related and distinct entities. Am J Ophthalmol. 2015;160:1-3.e2.
13. Rahimy E, Kuehlewein L, Sadda SR, Sarraf D. Paracentral acute middle maculopathy: What we knew then and what we know now. Retina. 2015;35:1921-1930.
14. Venkatesh R, Reddy NG, Mishra Pm et al. Spectral domain OCT features in type 2 macular telangiectasia (type 2 MacTel): Its relevance with clinical staging and visual acuity. Int J Retin Vitr. Published online April 5, 2022. doi: 10.1186/s40942-022-00378-0
15. Gass JD, Blodi BA. Idiopathic juxtafoveolar retinal telangiectasis. Update of classification and follow-up study. Ophthalmology. 1993;100:1536–1546.
16. Yannuzzi LA, Bardal AMC, Freund KB, Chen K-J, Eandi CM, Blodi B. Idiopathic macular telangiectasia. Arch Ophthalmol. 2006;124:450–460.
17. Charbel Issa P, Pauleikhoff D, Holz FG. Macular telangiectasia type 2: The international MacTel project. Ophthalmologe. 2014;111:817–818.
18. Baumal CR, Sarraf D, Bryant T, et al. Henle fiber layer haemorrhage: clinical features and pathogenesis. Br J Ophthalmol. 2021;105:374-380.
19. Au A, Hou K, Baumal CR, Sarraf D. Radial hemorrhage in Henle layer in macular telangiectasia type 2. JAMA Ophthalmol. 2018;136:1182-1185.